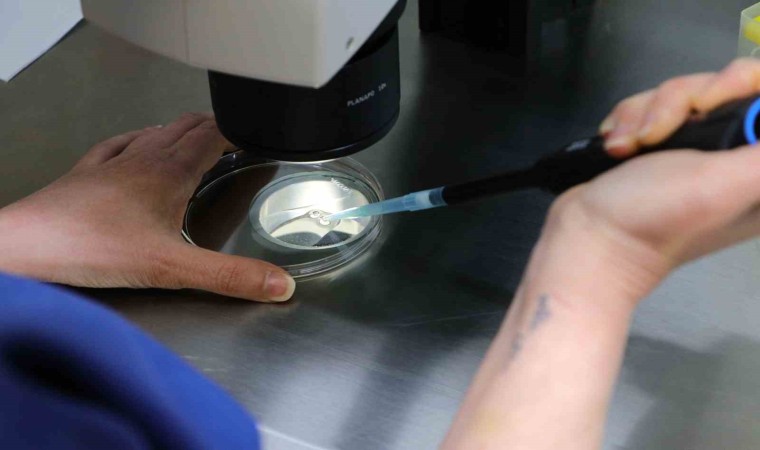

Adana Şehir Eğitim ve Araştırma Hastanesi’nde faaliyet gösteren ‘Üremeye Yardımcı Tedavi Merkezi’nde vatandaşlar devletin imkanlarıyla tüp bebek tedavisinden yararlanıyor. Bölgenin yükünü kaldıran merkeze 4 ayda bin 400 hasta başvurdu.
Adana Şehir Eğitim ve Araştırma Hastanesi’nde geçen 19 Eylül tarihinde hizmete alınan Üremeye Yardımcı Tedavi Merkezi’nde son teknolojik cihazlarla hizmet sunuluyor.
Merkezde, kadın ve erkekteki kısırlık nedenlerinin araştırılması amacıyla gerekli testler ve muayeneler, yumurtlama, aşılama, tüp bebek, mikroenjeksiyon, testiküler sperm ekstraksiyonu (TESE/Mikro TESE), embriyo ve gonad hücreleri dondurma işlemleri yapılıyor.
“Son teknoloji cihazlarla hizmet veriyoruz”
İhlas Haber Ajansı’na konuşan Üremeye Yardımcı Tedavi Merkezi Sorumlusu Kadın Hastalıkları ve Doğum Uzmanı Doç. Dr. Sefa Arlıer, yıllardır böyle bir merkezi hayal ettiklerini söyledi. Doç. Dr. Arlıer, “Bu yaklaşık bizim 10-12 yıllık hayalimiz. Bu bölgede depremden sonra Balcalı Hastanesi Tüp Bebek Merkezi kapandıktan sonra kamuda böyle bir ihtiyaç arttı. Biz de devlet eliyle burada yetişmiş elemanlarımızla, son teknoloji cihazlarla merkezimizi 3 ay önce açtık. Şu ana kadar bin 400 hasta başvurdu, tüp bebek için başvuran hastalarımız var, aşılama için başvuran hastalarımız var, tetkikleri devam eden hastalarımız var” dedi.
“Birçok ilden hastamız var”
Hastalardaki tedavi şansının da sevindirici olduğunu vurgulayan Doç. Dr. Sefa Arlıer, “Geçen ay 16 hastadan 8 tanesinden pozitif sonuç aldık. Çok sevindirici bir durum bu bizim için. Öte yandan, aşılama hastalarımızdan da yüzde 20’ye yakın bir başarı oranımız var ve her geçen gün halkın teveccühü ile başvurular artıyor. Van, Hatay, Mardin olmak üzere birçok ilden hastalarımız var” ifadelerini kullandı.
Doç. Dr. Nefise Tanrıdan Okcu ise devlet eliyle tüp bebek tedavisinin merkezde yapılabildiğini ve SGK katkı payı ödemelerinin hastadan hastaya değiştiğini söyledi.
“Başarı oranı yüzde 40”
Merkez ile ilgili teknik bilgiler veren Doç. Dr. Deniz Aka Satar, “Merkezin açılmasıyla birlikte çok sayıda hasta başvurmaya başladı. Ocak ayında 30 hasta başvurdu. Bu hastalarımızın sonuçlarını yeni yeni alıyoruz. Gebelik sonuçları çok memnun edici. Laboratuvarımız son teknoloji ve A kalite. Tüp bebek yaptığımız mikroskop tam otomatiktir ve lazeri vardır. Bu laboratuvar bakanlığın önerdiği bütün şartları sağlıyor. Bu tür laboratuvarlar arasında birinci sıradayız. Androloji laboratuvarımızda ise aylık çok hasta sayısına ulaştı. Androloji laboratuvarımızda 4 ay içinde 200’e yakın aşılama yaptık. Onda da başarı oranımız yüzde 40 oldu” dedi.

Yorum Yazın
E-posta hesabınız sitede yayımlanmayacaktır. Gerekli alanlar * ile işaretlenmişdir.